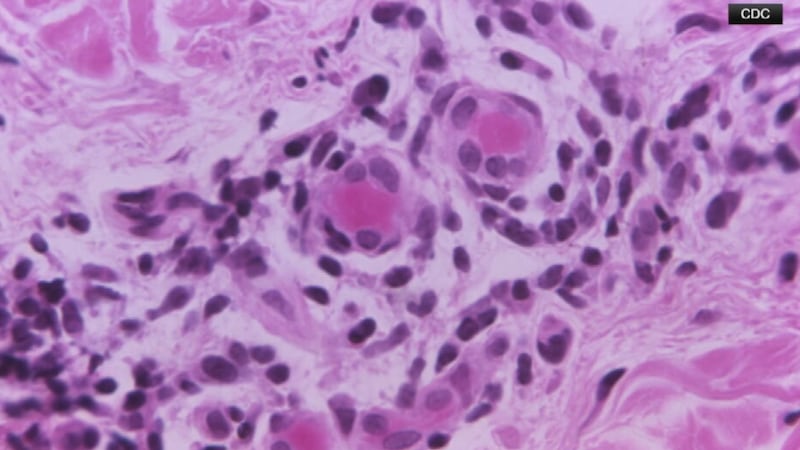
Georgia’s TB case numbers are soaring, worrying doctors

Latest Headlines by Karyn Greer
Derwin Brown assassination 25 years later: Former Channel 2 reporter was on same hit list
Monday marked 25 years since the assassination of DeKalb County Sheriff-Elect Derwin Brown, a murder that shocked Georgia and the nation days before Christmas.
Promoting teen empowerment: Jane Fonda among philanthropists reflecting on 30 years of state program
Renowned actress Jane Fonda has been dedicated to reducing teen pregnancy rates in Georgia for the past 30 years through her initiative, now known as the Georgia Campaign for Adolescent Power and Potential.
Are you job hugging? It’s not as cozy as it sounds
Experts say the rise of AI has many people worried about changing jobs.
Big Brothers Big Sisters of metro Atlanta celebrates milestone, seeking mentors to help the youth
Big Brothers Big Sisters of Metro Atlanta is seeking mentors to help guide hundreds of young people waiting for support, as highlighted at this week’s Legacy Luncheon.
Atlanta native to headline world-class tennis tournament back in his hometown
Ben Shelton says he is excited to bring world-class tennis back to Atlanta for the inaugural Atlanta Cup.
American Black Film Festival coming to Hollywood of the South
The festival's pop-up event will feature workshops and a premiere screening of "Power Book IV: Force."
Aviation expert calls UPS cargo plane crash ‘the worst I have ever heard’
The NTSB confirmed on Wednesday that the left wing and engine came off the plane prior to the crash.
Taste of Hartsfield returns to Atlanta’s airport, will benefit Meals on Wheels
Helping your neighbors is the thought behind a culinary celebration at the world’s busiest airport.